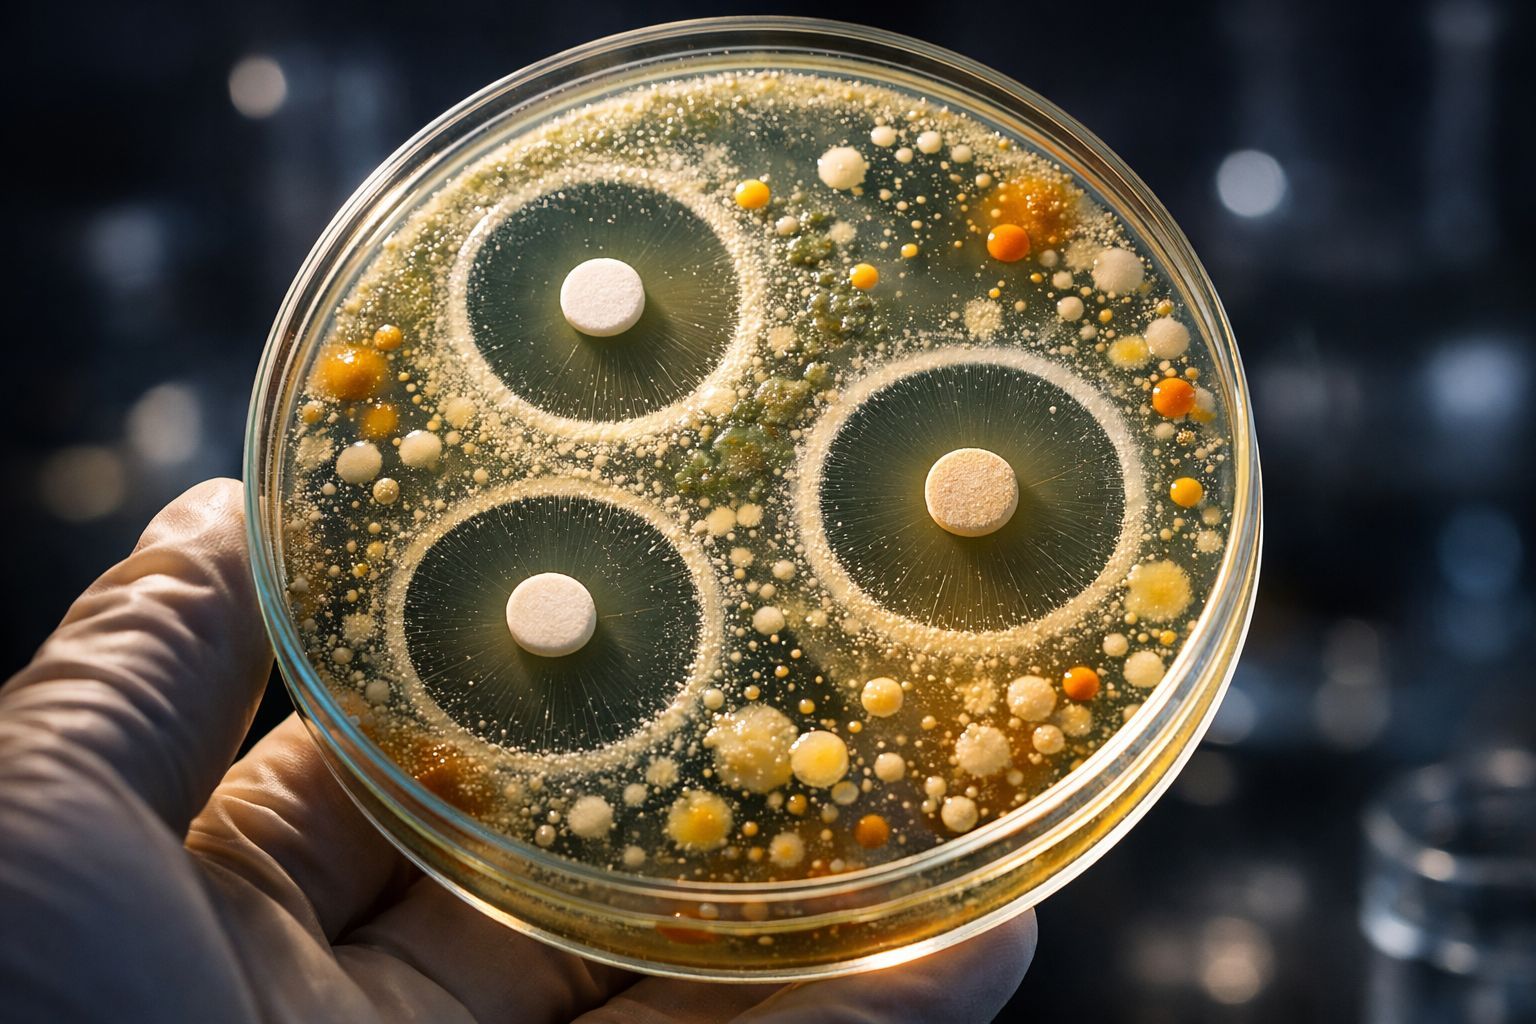

Une lueur d’espoir au fond de la ruche

On entend souvent dire que nos abeilles vont mal, et malheureusement, ce n’est pas une exagération. Ces petites sentinelles de notre biodiversité font face à une véritable avalanche de menaces. Imaginez un instant : on a identifié plus d’une trentaine d’agents pathogènes différents — des virus, des bactéries, des champignons et même des parasites — qui s’infiltrent dans les ruches. C’est un véritable siège permanent qui met en péril non seulement la santé des abeilles, mais par ricochet, notre sécurité alimentaire mondiale.
Le problème, c’est que nos armes actuelles s’émoussent. Les traitements classiques, comme les antibiotiques, perdent de leur efficacité ou causent d’autres dégâts. On se sent parfois un peu démunis face à ce constat, non ? Pourtant, une lueur d’espoir vient de surgir là où on ne l’attendait pas forcément. Une équipe de chercheurs du Washington College et de l’Université du Wisconsin-Madison a décidé de regarder le problème sous un autre angle.
Leurs travaux, qui viennent d’être publiés dans la très sérieuse revue Frontiers in Microbiology, ont mis en lumière quelque chose de fascinant : la solution pourrait se trouver dans le pollen lui-même. Il semblerait que certaines bactéries, présentes naturellement dans ces grains dorés, fabriquent leurs propres médicaments. Une découverte qui, si elle se confirme sur le terrain, pourrait bien bouleverser notre manière de protéger les ruches.
Une biodiversité invisible cachée dans les fleurs

On a tendance à voir le pollen simplement comme de la nourriture, une source de protéines vitale pour la colonie. Mais en réalité, c’est beaucoup plus complexe que ça. Ce n’est pas une matière stérile, loin de là ! C’est un milieu vivant, foisonnant. Les chercheurs ont mis les mains dans le cambouis — ou plutôt dans la ruche — en isolant précisément 34 souches d’actinobactéries à partir de pollen végétal et de celui stocké par les abeilles.
Et c’est là que ça devient intéressant : sur ces échantillons, 72 % appartiennent au genre Streptomyces. Si ce nom ne vous dit rien, sachez que c’est une célébrité dans le monde microbien pour sa capacité à produire des antimicrobiens. Le fait de retrouver ces bactéries à la fois dans les fleurs, sur les butineuses et dans la ruche suggère qu’il y a un transfert constant. Les abeilles, en faisant leurs courses, ramènent à la maison bien plus que du pollen : elles rapportent une armée de défenseurs microscopiques.
Mais attention, tout n’est pas rose. Cette diversité microbienne ne tombe pas du ciel ; elle dépend directement de la diversité des plantes aux alentours. C’est assez logique quand on y pense, mais cela confirme qu’une flore variée favorise une richesse en « bonnes » bactéries. À l’inverse, les monocultures, ces vastes étendues d’une seule plante, agissent probablement comme un désert pour cette ressource invisible. On réalise alors que le microbiome du pollen, qu’on a longtemps négligé, pourrait être un pilier central de la résilience des colonies.
Pour comprendre d’où viennent ces alliés, les scientifiques ont réalisé une analyse génomique poussée. Verdict ? Ce ne sont pas des touristes. Ces Streptomyces sont des endophytes, c’est-à-dire des symbiotes qui vivent à l’intérieur des tissus de la plante. Ils possèdent des gènes spécifiques — comme ceux produisant de l’auxine et des cytokinines (des hormones de croissance) ou des enzymes capables de dégrader la paroi cellulaire végétale. Ils savent aussi synthétiser des sidérophores, comme la desferrioxamine, pour capter le fer. C’est une interaction tripartite fascinante entre la plante, le microbe et l’insecte, un équilibre naturel parfait.
La contre-attaque biologique : des résultats prometteurs
Bon, c’est bien beau d’avoir des bactéries, mais sont-elles efficaces ? Les chercheurs n’ont pas fait les choses à moitié. Ils ont organisé des « combats » en laboratoire — des essais de compétition — contre six pathogènes majeurs. Trois d’entre eux s’attaquent aux abeilles : Aspergillus niger, Paenibacillus larvae et Serratia marcescens. Les trois autres visent les plantes : Erwinia amylovora, Pseudomonas syringae et Ralstonia solanacearum. Une belle brochette de nuisibles, n’est-ce pas ?
Les résultats sont assez bluffants. Presque toutes les souches de Streptomyces testées ont réussi à freiner la croissance d’Aspergillus niger. Ce champignon est particulièrement sournois : il cause la maladie du « stonebrood », une infection qui transforme les larves d’abeilles en petites momies dures comme de la pierre. C’est une image un peu effrayante, mais elle illustre bien le danger.
D’autres souches ont montré une activité allant de modérée à forte contre P. larvae, le responsable de la fameuse loque américaine. C’est une maladie bactérienne très contagieuse et mortelle pour les larves. Côté plantes, l’efficacité est aussi au rendez-vous contre les agents responsables de flétrissements ou de pourritures qui ravagent les cultures de pommes de terre, de tomates ou de pommiers.
Mais comment font-elles ? Ces bactéries sont de véritables petites usines chimiques. Elles produisent des métabolites bioactifs aux noms un peu barbares comme les PoTeMs (macrolactames polycycliques), les surugamides, les lobophorines ou encore les sidérophores dont on parlait plus tôt. Ces composés ont l’avantage d’être stables, peu toxiques pour les autres organismes et d’avoir un large spectre d’action. C’est la nature qui fait le travail de la pharmacologie, en quelque sorte.
Conclusion : Vers une apiculture (et une agriculture) plus saine ?

Aujourd’hui, quand une ruche est malade, on se tourne souvent vers deux antibiotiques : l’oxytétracycline et la tylosine. C’est mieux que rien, me direz-vous, mais cela pose de sérieux problèmes. On parle d’effets secondaires sur le microbiote des abeilles, de contamination possible du miel et de la cire, et surtout, de résistance. Certaines souches de Paenibacillus larvae se moquent déjà de l’oxytétracycline. Il est donc urgent de trouver autre chose.
L’idée qui émerge de cette étude est pleine de bon sens : pourquoi ne pas réintroduire ces bactéries bénéfiques ? On pourrait imaginer inoculer des souches spécifiques de Streptomyces dans les ruches, via le pollen ou d’autres préparations. Ce serait une sorte de probiotique sur mesure, une stratégie biologique ciblée qui respecte l’écologie de la colonie.
Et cela va même au-delà des abeilles. Puisque ces mêmes bactéries protègent aussi les plantes, ces découvertes ouvrent la voie à une agriculture plus résiliente, moins dépendante des pesticides de synthèse. Finalement, cette étude nous rappelle une leçon essentielle : la santé de nos pollinisateurs et celle de nos cultures sont intimement liées. En protégeant la diversité florale, on entretient ce réseau invisible de symbioses qui, en silence, protège le vivant.
Selon la source : science-et-vie.com
Ce contenu a été créé avec l’aide de l’IA.